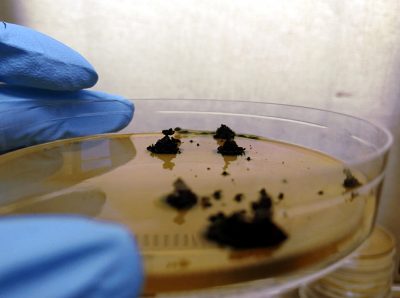
4-Volcanes_del_desierto

Volcanes del desierto
Publicada el 22/01/2026
Título: Volcanes del desierto
Autor: Lorena Carro García
Plaza Doctores de la Reina, s/n, Edificio Departamental de Biología, 37007 Salamanca
Descripción: Colonias de una actinobacteria aislada del desierto de Atacama (Chile) que se desarrollan sobre un medio rico formando unas estructuras características en forma de volcán.